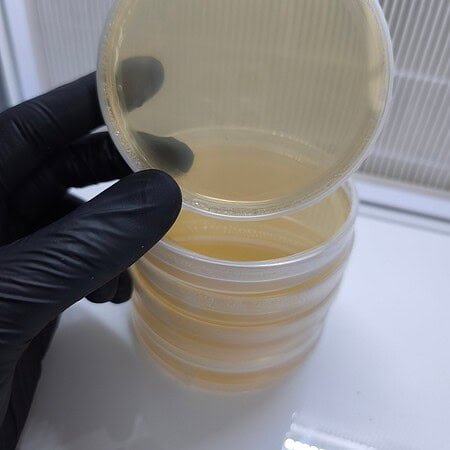
boites de pétri

Kits , substrats et mycéliums prêts à pousser

Quelques mots sur nous
Une boutique de passionnés, pour les passionnés de champignons
Achetez des produits naturels, durables et de qualité autour de la culture et de la découverte des champignons.
Nous sommes une communauté grandissante de cultivateurs, amateurs et curieux qui souhaitent apprendre, partager et faire pousser un monde plus vert.
Notre objectif est simple : proposer des spores, mycéliums et matériels fiables, inspirer la culture responsable et transmettre le savoir-faire fongique.
Terrafungi est un espace collaboratif, durable et transparent, bâti sur la passion, la confiance et le respect de la nature.
Choisissez vos myceliums
Sélectionnez vos spores, mycéliums ou kits de culture pour démarrer facilement.

Cultivez vos champignons
Suivez nos conseils et utilisez notre matériel pour voir grandir vos cultures à la maison.

Récoltez & savourez
Profitez de champignons frais, sains et naturels, cultivés par vos soins.

Dernières arrivées
Nouveautés

Pourquoi nous
Faites la différence
Découvrez des champignons frais, spores et mycéliums de qualité, cultivés avec passion et sans produits chimiques. Chez Terrafungi, nous favorisons la culture durable et le savoir-faire artisanal pour vous offrir des variétés uniques, nutritives et savoureuses.
Des spores, mycéliums et champignons cultivés sans produits chimiques ni pesticides, pour une expérience saine et authentique.
Nous privilégions des méthodes de myciculture respectueuses de l’environnement, inspirées de la nature et du savoir-faire artisanal.
Chaque variété est sélectionnée avec soin pour garantir des champignons vigoureux, frais et nutritifs.